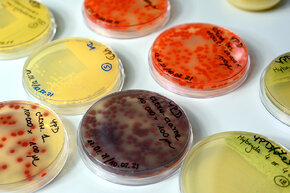
Z10_5657 900X600.jpg
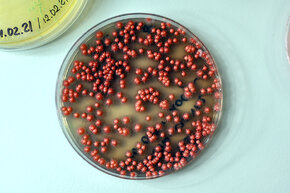
Z10_5672 900X600.jpg

Unikatowa platforma do produkcji białek wykorzystująca psychrotolerancyjne drożdże
Podpisana została kolejna umowa licencyjna na wynalazek z dziedziny biotechnologii stworzony przez naukowców z Politechniki Gdańskiej i Politechniki Łódzkiej. Chodzi o platformę, która umożliwia produkcję białek w oparciu o system ekspresji genów w wyselekcjonowanym gatunku drożdży przystosowanym do wzrostu w niskich temperaturach. To unikatowe rozwiązanie może znaleźć zastosowanie m.in. przy produkcji biofarmaceutyków czy enzymów działających w niskich temperaturach przydatnych do produkcji np. związków zapachowych lub środków piorących w zimnej wodzie.
– Stworzyliśmy narzędzie, które umożliwia wyprodukowanie teoretycznie każdego białka. Do wyselekcjonowanych drożdży można wprowadzić gen z dowolnego organizmu. Oczywiście w praktyce może się okazać, że nie każde białko da się ostatecznie w ten sposób wyprodukować, ale dzięki naszemu rozwiązaniu, można podejmować takie próby – mówi dr hab. inż. Marta Wanarska, prof. uczelni z Katedry Biotechnologii Molekularnej i Mikrobiologii Wydziału Chemicznego PG. – Jesteśmy jednym z nielicznych zespołów naukowców w Polsce zajmujących się inżynierią genetyczną drożdży, które są o wiele bardziej wymagające i kapryśne niż np. bakterie – dodaje prof. Marta Wanarska.
Dotychczas do wydajnej produkcji rekombinantowych białek (np. enzymów wykorzystywanych do produkcji leków i żywności, będących składnikami środków czystości, bądź białek badanych w ramach badań podstawowych) zarówno firmy biotechnologiczne, jak i liczne ośrodki naukowe stosowały systemy ekspresji genów bazujące na drobnoustrojach, które efektywnie przeprowadzają w swoich komórkach procesy metaboliczne w temperaturze ≥ 30 ̊C. Zaletą opracowanego systemu jest jego przydatność do produkcji rekombinantowych białek, co do których wiadomo, że temperatura ≥ 30 ̊C ma negatywny wpływ na wydajność ich biosyntezy i oczekiwane właściwości.
– Produkcja białek w niskiej temperaturze jest czasem bardziej wydajna również w przypadku takich, które można efektywnie wytwarzać w wyższej temperaturze. Jest też bardziej ekonomiczna i mniej obciążająca dla środowiska, ponieważ przenosząc proces do niższej temperatury czynimy go mniej energochłonnym – mówi dr hab. inż. Hubert Cieśliński, prof. uczelni.
Kolejna umowa licencyjna z firmą biotechnologiczną
Właśnie została podpisana kolejna umowa licencyjna na ten wynalazek z gdańską firmą Blirt S.A., specjalizującą się w wytwarzaniu wysokiej jakości enzymów oraz odczynników dedykowanych do stosowania w Life Scence. Wcześniej umowę licencyjną zawarto z firmą A&A Biotechnology z Gdyni. Nad przygotowaniem i negocjacją warunków obydwu umów pracowali: mgr inż. Robert Bajko z Centrum Transferu Wiedzy i Technologii PG, radca prawny Joanna Ratasiewicz z Biura Obsługi Prawnej Własności Intelektualnej i Projektów PG oraz rzecznik patentowy dr Justyna Pawłowska z Zespołu Rzeczników Patentowych PG.
Politechnikę Gdańską podczas podpisania umowy reprezentował prof. Janusz Nieznański, prorektor ds. umiędzynarodowienia i innowacji, natomiast firmę Blirt S.A. Marian Popinigis, prezes zarządu oraz dr inż. Krzysztof Kur, wiceprezes.
– Jako firma biotechnologiczna wytwarzająca enzymy i inne białka w skali przemysłowej, zamierzamy sprawdzić możliwości produkcyjne nowych szczepów do wytworzenia wybranych enzymów wykorzystywanych w diagnostyce molekularnej lub produkcji biofarmaceutyków. Liczymy, że omawiany system ekspresyjny pozwoli uzyskać znacznie lepszą produktywność szczególnie w przypadku nadekspresji enzymów termolabilnych, działających w niskich temperaturach, pochodzących z organizmów psychrotolerancyjnych lub psychrofilnych – mówi dr inż. Krzysztof Kur.
W spotkaniu uczestniczyli także dr hab. inż. Marta Wanarska i dr hab. inż. Hubert Cieśliński, Damian Kuźniewski, dyrektor Centrum Transferu Wiedzy i Technologii PG oraz Robert Bajko z CTWiT.
Zespół badawczy
Wynalazek został zgłoszony w europejskiej procedurze patentowej EPO w 2018 r. W skład zespołu badawczego ze strony Politechniki Gdańskiej weszli: prof. dr hab. Józef Kur* kierownik i wnioskodawca projektu, dr hab. inż. Marta Wanarska, prof. uczelni, dr hab. inż. Hubert Cieśliński, prof. uczelni, dr inż. Ewelina Krajewska, dr inż. Monika Wicka-Grochocka, dr inż. Anna Pawlak-Szukalska oraz mgr inż. Natalia Filipowicz z Katedry Biotechnologii Molekularnej i Mikrobiologii Wydziału Chemicznego. Natomiast twórcami wynalazku z Politechniki Łódzkiej są: prof. dr hab. Marianna Turkiewicz, dr hab. inż. Aneta Białkowska, mgr inż. Ewa Gromek, dr inż. Joanna Krysiak oraz dr inż. Tomasz Florczak z Instytutu Biochemii Technicznej Wydziału Biotechnologii i Nauk o Żywności.
* Profesor dr hab. Józef Wojciech Kur (1955–2016) był wieloletnim kierownikiem Katedry Mikrobiologii (później Katedry Biotechnologii Molekularnej i Mikrobiologii) Wydziału Chemicznego PG.
Kontakt:
Patryk Rosiński
Rzecznik prasowy
Politechnika Gdańska